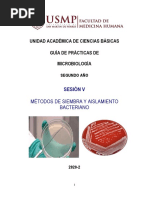
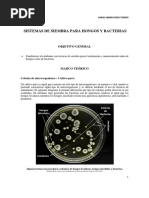

0% encontró este documento útil (0 votos)
179 vistas21 páginasInforme
Este documento presenta los resultados de un laboratorio de microbiología ambiental sobre métodos de siembra. Se utilizaron agares con papa para cultivar hongos de frutas en descomposición y agares de glucosa para bacterias de agua contaminada. Se describen técnicas como siembra en estría en placa, siembra masiva y microcultivo. El objetivo era identificar y aplicar métodos de siembra para facilitar el estudio de colonias microbianas.
Cargado por
YuleisDerechos de autor
© © All Rights Reserved
Nos tomamos en serio los derechos de los contenidos. Si sospechas que se trata de tu contenido, reclámalo aquí.
Formatos disponibles
Descarga como DOCX, PDF, TXT o lee en línea desde Scribd
0% encontró este documento útil (0 votos)
179 vistas21 páginasInforme
Este documento presenta los resultados de un laboratorio de microbiología ambiental sobre métodos de siembra. Se utilizaron agares con papa para cultivar hongos de frutas en descomposición y agares de glucosa para bacterias de agua contaminada. Se describen técnicas como siembra en estría en placa, siembra masiva y microcultivo. El objetivo era identificar y aplicar métodos de siembra para facilitar el estudio de colonias microbianas.
Cargado por
YuleisDerechos de autor
© © All Rights Reserved
Nos tomamos en serio los derechos de los contenidos. Si sospechas que se trata de tu contenido, reclámalo aquí.
Formatos disponibles
Descarga como DOCX, PDF, TXT o lee en línea desde Scribd